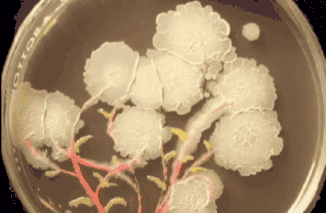
图片

又是一年换季时,各位姐妹已经开始在各大平台搜罗,恨不得“种下一片草原”,将新衣服塞满整个衣柜。
那么,换一件新内裤有没有在你的清单里呢?

有人穿着成百上千的衣服,却对贴身衣物毫不在意:
随意选择来源不明10块钱三条的地摊产品或者穿到发黄发硬甚至烂掉也懒得换。

怪不得下面总会有湿哒哒黏糊糊的异物。
再碰上经期到访,不用脱下内裤都能闻到一股恶心的鱼腥味!

千万别刻板的认为:妇科病=性生活混乱!
“私生活不干净的人才会有这种病”
❗妇科病≠私生活
“妇科病都是男人带来的”
❗妇科病≠性不洁
“是她谈的男朋友太多,才会得病”
❗妇科病≠非chu女

据世卫组织调查发现,80%的妇科疾病都是由于脏内裤引起的。
穿过一天的内裤,上面的细菌高达1000000个,其中不乏直接可导致妇科炎症的大肠杆菌、金黄色葡萄球菌、和白色念珠菌。


内裤的保质期就三个月
超过这个时间就不能再称为内裤了
只是一块脏兮兮的布!!!
(再穿下去可能是成片的细菌窝)

所以赶紧看看你的柜子里有没有“过期内裤”,是时候跟上换季换新衣的节奏了~
❓如果你对挑选内裤不在行,请跟紧我这个“内裤大户”的步伐:

今天想跟大家分享的这款,是我一周穿7天的/星期内裤/:
月销量16000+
好评率98%

先说大家最关心的价格❗
性价比超高,49/盒(7条装),这个价格当一次性内裤穿都毫无压力。
只有2000盒的尝鲜价,买到的姐妹就是赚到!

选择再次推给大家,不仅仅是因为第一代卖得好
更是因为它符合我对内裤的所有预期:
艾草纤维抑菌底裆#舒适透气
高弹60支莫代尔面料#无痕隐形
甜甜软软的冰淇淋色系#温柔可人

款式简约,自带一个礼盒包装手提袋,刚拿到手就让你Feel到高级感满分。

面料很扎实&舒服,拿到手上都会忍不住蹭蹭~
甄选60支莫代尔裸感体验
贴着肌肤软软糯糯的

面料是偏向「雾面磨毛」的质感:
让它在手感丝滑的基础上又有种毛茸茸的暖意,即使在有冷意的秋冬穿,也不会接触到皮肤就凉到乍一颤。

它还是大多数女生都很喜欢的中腰设计;
可以把小肚腩轻轻兜住。

❗重点是不夹臀
过于高腰的隐形性不好,一不小心就出来“丢人现眼”;低腰的稍微一动就溜到PP中间膈应人。
它的高度设计正好是最舒服的,美观又无感的存在~

还有它的加分隐藏技能--艾草底裆
一种有生命的颜色,让你最娇嫩的肌肤远离工业污染。
抑菌净化 告别瘙痒
即便是大家认为最健康的纯棉内裤❗
穿久了用手一搓,断掉的纤维犹如天女散花,贴身穿飞到阴道里,影响黏膜造成感染。

而「完美有约」在最关键的裆部也是工艺最为复杂的地方做了“保护层”。

①在底裆中加入了艾草植萃精华:
艾草向来被叫做“女性保护草”,现代医学药理也研究表明:艾草能很好的击杀有害菌,并抑制私处脏东西的滋生,保持裆部持久干爽。
滴入艾草原液,可以看到有害菌“消失”
你看温变前后对比,正是因为艾草精华直接“织”入布里,在细菌和私处之间建立了一个“金钟罩”。

②高温煮洗杀菌。
出品前用100℃的高温煮洗杀菌,再由60℃的暖风快速风干,让每条内裤在出厂之前都是无菌干净状态。
从采集的菌群样本可见用艾草植萃制成底裆的内裤可以踏踏实实的减少细菌滋生,更能给私处长效保护。

之前穿其他内裤总会觉得自己有异味,但现在觉得自己是一个「从里到外」都精致的女孩子。

抑菌效果也是通过了第三方检测机构的认证,对私处中常见的金黄色葡萄球菌、大肠杆菌、白色念珠菌都有很强的抑制作用。

即便是水洗50次后,抑菌净化力依旧可以达到国家认证的5A级。

经常下面瘙痒有异味的人,穿上一段时间会发现,瘙痒感没了,私处干爽透气,就连异味、私处潮湿也能逐渐消失。

精致的内裤 细节也加分
今天再给大家“打个假”:
在大家的传统观念里,内裤全身都是纯棉的就是蕞好的,舒服又透气,但是我们都忽略了它的一个致命缺点!!!
打湿后不容易变干,而恰好细菌就最喜欢在潮湿闷热的环境里生存,久而久之成为妇科病的『隐形杀手』。

别以为我是在道听途说,根据国家标准来看,纯棉的无论透气还是排汗性都很弱!

数据来源:丁香医生;
*「公定回潮率」代表纤维的吸湿能力,数值越高吸湿性越强。
完美有约选的是回潮率蕞好的粘纤保证吸湿+干爽。

再加上普通内裤无法比拟的透气性,穿上感觉PP很自由~
别说生理期多加一层了,到了秋冬几条大棉裤叠穿都不会让人觉得捂得慌!

这个底裆还有一个好处就是特别好清洗!
底裆沾染的污渍、姨妈血、尿液、分泌物轻轻一搓就掉了,绝不留一丝“导火索”。

它凭借自己的实力,俘获了众多芳心:
很多女生穿过以后都表示
不想再穿回普通内裤了~

立体包裹剪裁 完美贴合PP
有一阵维密风刮得很大,秉承着一分钱一分货的理念,跟小姐妹下“重本”买了一件100+的内裤。

没想到美则美矣,但穿上身丝毫不影响它的鸡肋!
(有句话怎么说来着:奢侈品从来不坑穷人
)兴致勃勃穿着它出门约会,没走两步就开始夹屁股!真的尴尬到抠出三室一厅。

完美有约这款内裤就完全不会有这种困扰!
品牌方引进了德国先进的一片式技术,避免了难看的拼接和线头外冒。

整件的腰身一片式剪裁
轻薄无痕

裤腿蕾丝边的衔接处理也很好,贴合人体曲线

穿上之后比起那些「和它看起来差不多的普通内裤」:
它更能严丝合缝的包裹住臀部。

它对各种身材的包容度也很OK
我生完孩子后肚子很多肉肉,大腿也变粗,内裤没选好的话

*大家是不是也有疑问为什么之前很多内裤的弹力展示只有横向的?直到今天我才悟到,这就是卡裆的原因所在!!!
这款内裤任由你前后左右、上扯下拉弹力都大到离谱

只有这样的内裤,腰腹+大腿根的肉肉才不会被“勒成游泳圈”,更不会卡裆、夹屁股。

七个耐看的冰淇淋色系
最后的最后想跟大家说:“尽管放心买回去,拿到手只会比实拍图好看并且好穿”

轻微若隐若现的面料,是专属少女的甜美温油~

比起市面上那些花里胡哨、中看不中用的内裤。
它真的能打破你对“舒服的内裤=老气的大妈款”的错误认知!

每盒都是做的很治愈的七个颜色:
香草绿、奶油肤、嫩粉色、香芋紫、果酱粉、香芒黄、海盐蓝

虽然只做了均码,但体重80~135斤都是可以穿的。

一组7条/盒的价格,真的建议姐妹们可以多买几盒!出差/旅游当次抛都不心疼~
花几百上千买衣服化妆品的同时,请花一点点小钱重视我们的“内在”!!!
单条市场价格¥25
今天给大家争取到的价格:¥49/盒
还是礼盒包装!


